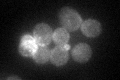
YLR414C
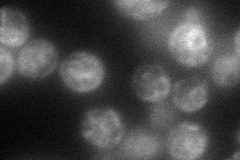
YLR414C
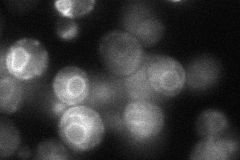
YLR414C
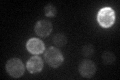
YLR414C

View description
Putative protein of unknown function; localizes to bud and cytoplasm; co-localizes with Sur7p in punctate patches in the plasma membrane; null mutant displays decreased thermotolerance; transcription induced on cell wall damage
Localization:
Intensity:
Fold change:
Significance:
-
C’ GFP library in SD
cell periphery42.01 -
N' NOP1pr-GFP in SD
ER71.3443 -
N' TEF2pr-mCherry in SD

below threshold5.70521 -
N' NATIVEpr-GFP in SD
ER37.2464 -
N' TEF2pr-VC and Cyto-VN in SD

#N/A0 -
C’ GFP library in SD+DTT

cell periphery227.75.41Yes -
C’ GFP library in SD+H2O2

cell periphery420.99No -
C’ GFP library in Starvation Media
cell periphery38.150.9No -
C’ GFP library on the background of Pup2-DaMP

cell periphery -
C’ GFP library on the background of CCT mutant

cell periphery41.70460.992458No
